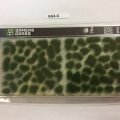
Photo of Gamer's Grass Green 4mm Tufts (GG4-G)

Gamers Grass - Tufts (88 products found)
See all Gamers Grass
Sub-categories:
You are on page 2 of 6

GG2-MO - Gamer's Grass Moss
Our Price:£4.65

GG4-BE - Gamer's Grass Biege 4mm Tufts
Our Price:£4.65

GG4-B - Gamers Grass Brown Tufts
Our Price:£4.65
GG4-G - Gamer's Grass Green 4mm Tufts
Our Price:£4.65

GG4-LG - Gamer's Grass Lt Green 4mm Tufts
Our Price:£4.65

GG4-SW - Gamer's Grass Swamp Tufts
Our Price:£4.65

GG5-AU - Gamer's Grass Autumn Tufts
Our Price:£4.65

GG5-W - Gamers Grass Winter Tufts
Our Price:£4.65

GG6-BE - Gamers Grass Beige Tufts
Our Price:£4.65

GG6-BUR - Gamer's Grass Burned Tufts
Our Price:£4.65

GG6-DG - Gamers Grass Dry Green Tufts
Our Price:£4.65

GG6-DT - Gamers Grass Dry Tufts
Our Price:£4.65

GG6-LB - Gamer's Grass Light Brown Tufts
Our Price:£4.65

GG6-LG - Gamers Grass Light Green Tufts
Our Price:£4.65

GG6-MG - Gamers Grass Mixed Green Tufts
Our Price:£4.65
